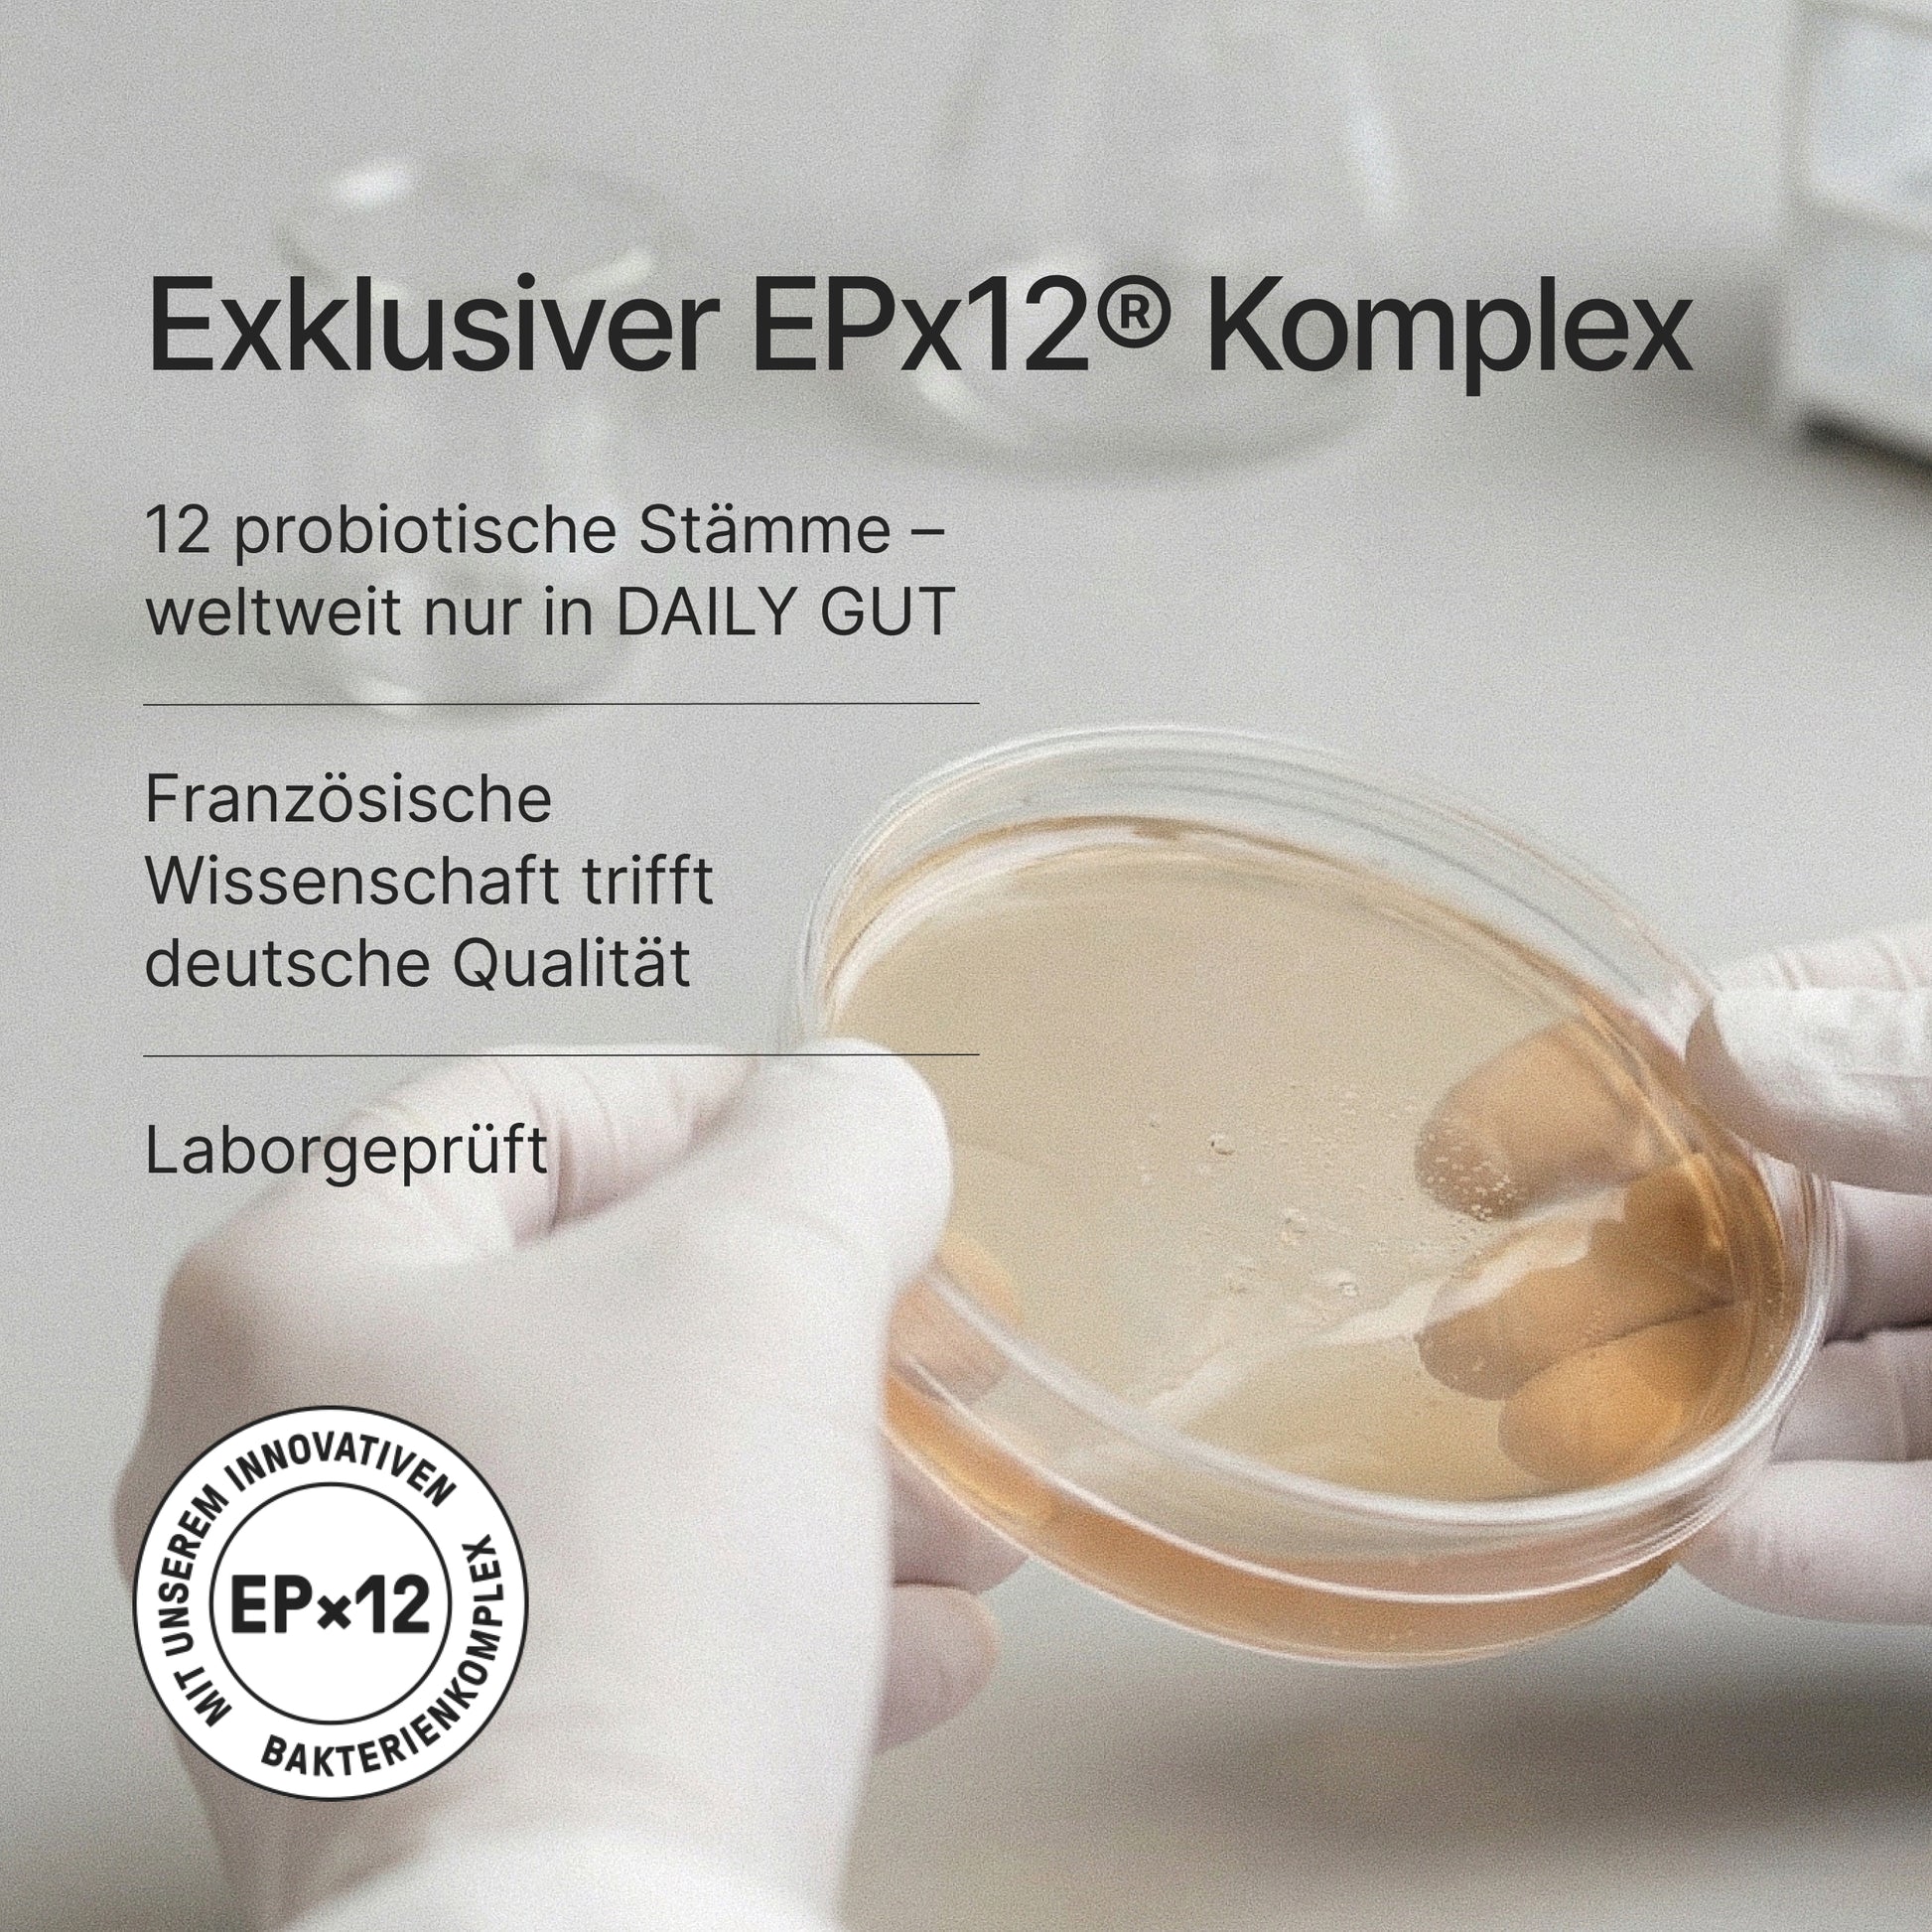

DAILY GUT Erdbeere:
Nahrungsergänzungsmittel in Pulverform mit Vitaminen, Milchsäurebakterien, Bifidobakterien, Mönchsfrucht-Extrakt und Süßungsmittel (240 g / 30 Portionen pro Packung).
DAILY GUT Erdbeere enthält:
Resistentes Maisdextrin, Akazienfaser, Säuerungsmittel: Citronensäure; L-Tyrosin, färbendes Lebensmittel: Rote Bete-Saftpulver; natürliches Aroma, EPx12®** Bakterienmischung (Bifidobacterium lactis, Lactobacillus paracasei, Lactobacillus plantarum, Lactobacillus casei, Bifidobacterium longum, Lactobacillus acidophilus, Lactobacillus brevis, Lactobacillus rhamnosus, Bifidobacterium infantis, Bifidobacterium breve, Lactobacillus bulgaricus, Bifidobacterium bifidum), 1% Erdbeerfruchtpulver (Erdbeeren, Maltodextrin, Säureregulator: Citronensäure), konzentriertes Mönchsfrucht- Extrakt, Süßungsmittel: Steviolglycoside (aus Stevia); Farbstoff: Beta-Carotin; Vitamin B12, Vitamin B6, Riboflavin, Thiamin.
| Inhaltsstoffe |
pro 8 g (Tagesdosis) |
% NRV* |
| Lactobacillus & Bifidobacterium (EPx12®**) |
16 Mrd. Kbe |
*** |
| Thiamin (Vitamin B1) |
0,21 mg |
15 % |
| Vitamin B2 (Riboflavin) |
0,16 mg |
15 % |
| Vitamin B6 |
0,21 mg |
15 % |
| Vitamin B12 |
0,38 ug |
15 % |
|
|
|
| Durchschnittliche Nährwerte |
pro 100 g |
pro 8 g |
| Energie (kj/kcal) |
886/217 |
71/17 |
| Fett (g) |
<0,5 |
<0,5 |
| - davon gesättigte Fettsäuren (g) |
<0,1 |
<0,1 |
| Kohlenhydrate (g) |
12 |
1,0 |
| - davon Zucker (g) |
2,6 |
0,2 |
| Ballaststoffe |
74 |
5,9 |
| Eiweiß (g) |
1,4 |
0,1 |
| Salz (g) |
0,06 |
<0,01 |
*Nährstoffbezugswerte gemäß EU-Verordnung 1169/2011
**EPx12® ist eine eingetragene Wortmarke der Whitewall GmbH
***Keine Referenzmenge vorhanden
DAILY GUT Zitrone:
Nahrungsergänzungsmittel in Pulverform mit Vitaminen, Milchsäurebakterien, Bifidobakterien, Mönchsfrucht-Extrakt und Süßungsmittel (240 g / 30 Portionen pro Packung).
DAILY GUT Zitrone enthält:
Resistentes Maisdextrin, Akazienfaser, Säuerungsmittel: Citronensäure, Äpfelsäure; L-Tyrosin, 2,0% Zitronensaftpulver (Maltodextrin, Zitronensaftkonzentrat), EPx12®** Bakterienmischung (Bifidobacterium lactis, Lactobacillus paracasei, Lactobacillus plantarum, Lactobacillus casei, Bifidobacterium longum, Lactobacillus acidophilus, Lactobacillus brevis, Lactobacillus rhamnosus, Bifidobacterium infantis, Bifidobacterium breve, Lactobacillus bulgaricus, Bifidobacterium bifidum), konzentrierter Mönchsfrucht-Extrakt, Süßungsmittel: Steviolglycoside (aus Stevia); natürliches Aroma, Farbstoff: Beta-Carotin; Vitamin B12, Vitamin B6, Riboflavin, Thiamin.
| Inhaltsstoffe |
pro 8 g (Tagesdosis) |
% NRV* |
| Lactobacillus & Bifidobacterium (EPx12®**) |
16 Mrd. Kbe |
*** |
|
Thiamin (Vitamin B1) |
0,21 mg |
15 % |
| Riboflavin (Vitamin B2) |
0,16 mg |
15 % |
| Vitamin B6 |
0,21 mg |
15 % |
|
Vitamin B12 |
0,38 μg |
15 % |
|
|
|
| Durchschnittliche Nährwerte |
pro 100 g |
pro 8 g |
| Energie (kj/kcal) |
877/215 |
70/17 |
| Fett (g) |
<0,5 |
<0,5 |
| - davon gesättigte Fettsäuren (g) |
<0,1 |
<0,1 |
| Kohlenhydrate (g) |
11 |
0,9 |
| - davon Zucker (g) |
2,0 |
0,2 |
| Ballaststoffe |
75 |
6,0 |
| Eiweiß (g) |
1,4 |
0,1 |
| Salz (g) |
0,06 |
<0,01 |
*Nährstoffbezugswerte gemäß EU-Verordnung 1169/2011
**Keine Referenzmenge vorhanden
***EPx12® ist eine eingetragene Wortmarke der Whitewall GmbH
DAILY GUT Neutral:
Nahrungsergänzungsmittel in Pulverform mit Vitaminen, Milchsäurebakterien und Bifidobakterien (240 g / 30 Portionen pro Packung).
DAILY GUT Neutral enthält:
Resistentes Dextrin, Akazienfaser, L-Tyrosin, EPx12®** Bakterienmischung (Lactobacillus brevis, Lactobacillus bulgaricus, Lactobacillus casei, Lactobacillus paracasei, Bifidobacterium longum, Bifidobacterium infantis, Bifidobacterium lactis, Bifidobacterium breve, Lactobacillus rhamnosus, Lactobacillus acidophilus, Bifidobacterium bifidum, Lactobacillus plantarum), Riboflavin, Vitamin B6, Thiamin, Vitamin B12.
| Nährstoffe und sonstige Stoffe |
pro 8 g (Tagesdosis) |
% NRV* |
| Lactobacillus & Bifidobacterium (EPx12®**) |
16 Mrd. Kbe |
*** |
|
Thiamin (Vitamin B1) |
0,21 mg |
15 % |
| Riboflavin (Vitamin B2) |
0,16 mg |
15 % |
| Vitamin B6 |
0,21 mg |
15 % |
|
Vitamin B12 |
038 μg |
15 % |
|
|
|
| Durchschnittliche Nährwerte |
pro 100 g |
pro 8 g |
| Energie (kj/kcal) |
909/223 |
73/18 |
| Fett (g) |
<0,5 |
<0,5 |
| - davon gesättigte Fettsäuren (g) |
<0,1 |
<0,1 |
| Kohlenhydrate (g) |
15 |
1,2 |
| - davon Zucker (g) |
0,4 |
<0,1 |
| Ballaststoffe |
79 |
6,3 |
| Eiweiß (g) |
1,5 |
0,1 |
| Salz (g) |
0,06 |
<0,01 |
*Nährstoffbezugswerte gemäß EU-Verordnung 1169/2011
**Keine Referenzmenge vorhanden
***EPx12® ist eine eingetragene Wortmarke der Whitewall GmbH
DAILY GUT Vanille:
Nahrungsergänzungsmittel in Pulverform mit Vitaminen, Milchsäurebakterien, Bifidobakterien, Mönchsfrucht-Extrakt und Süßungsmittel (240 g / 30 Portionen pro Packung).
DAILY GUT Vanille enthält:
Resistentes Maisdextrin, Akazienfaser, natürliches Aroma, L- Tyrosin, EPx12®** Bakterienmischung (Bifidobacterium lactis, Lactobacillus paracasei, Lactobacillus plantarum, Lactobacillus casei, Bifidobacterium longum, Lactobacillus acidophilus, Lactobacillus brevis, Lactobacillus rhamnosus, Bifidobacterium infantis, Bifidobacterium breve, Lactobacillus bulgaricus, Bifidobacterium bifidum), Salz, konzentriertes Mönchsfrucht-Extrakt, 0,5% entaromatisiertes Vanillepulver, Süßungsmittel: Steviolglycoside (aus Stevia); Vitamin B12, Vitamin B6, Riboflavin, Thiamin.
| Inhaltsstoffe |
pro 8 g (Tagesdosis) |
% NRV* |
| Lactobacillus & Bifidobacterium (EPx12®**) |
16 Mrd. Kbe |
*** |
|
Thiamin (Vitamin B1) |
0,21 mg |
15 % |
|
Riboflavin (Vitamin B2) |
0,16 mg |
15 % |
| Vitamin B6 |
0,21 mg |
15 % |
| Vitamin B12 |
0,38 μg |
15 % |
| Durchschnittliche Nährwerte |
pro 100 g |
pro 8 g |
| Energie (kj/kcal) |
867/213 |
69/17 |
| Fett (g) |
<0,5 |
<0,5 |
| - davon gesättigte Fettsäuren (g) |
<0,1 |
<0,1 |
| Kohlenhydrate (g) |
13 |
1,0 |
| - davon Zucker (g) |
2,2 |
0,2 |
| Ballaststoffe |
77 |
6,2 |
| Eiweiß (g) |
1,4 |
0,1 |
| Salz (g) |
0,67 |
0,05 |
*Nährstoffbezugswerte gemäß EU-Verordnung 1169/2011
**Keine Referenzmenge vorhanden
***EPx12® ist eine eingetragene Wortmarke der Whitewall GmbH